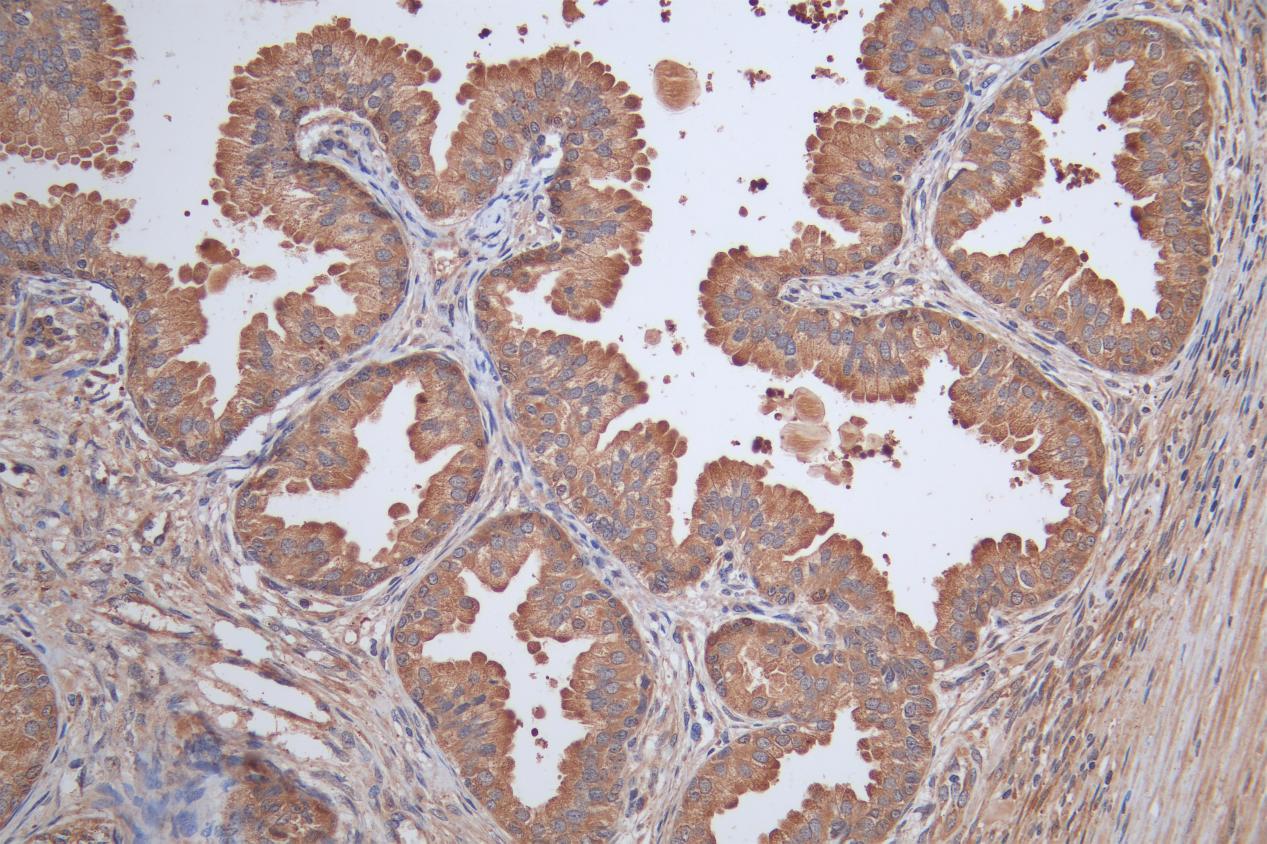

-
中文名稱:CHRNA2兔多克隆抗體
-
貨號:CSB-PA621886ESR1HU
-
規格:¥440
-
圖片:
-
Western Blot
Positive WB detected in: HL-60 whole cell lysate(20μg), Hela whole cell lysate(20μg), Jurkat whole cell lysate(20μg), PC-3 whole cell lysate(20μg)
All lanes: CHRNA2 antibody at 1:1000
Secondary
Goat polyclonal to rabbit IgG at 1/40000 dilution
Predicted band size: 59 kDa
Observed band size: 60 kDa
Exposure time: 300s -
Immunohistochemistry image of CSB-PA621886ESR1HU diluted at 1:50 and staining in paraffin-embedded human prostate tissue performed on a Leica BondTM system. After dewaxing and hydration, antigen retrieval was mediated by high pressure in a citrate buffer (pH 6.0). Section was blocked with 10% normal goat serum 30min at RT. Then primary antibody (1% BSA) was incubated at 4°C overnight. The primary is detected by a Goat anti-rabbit polymer IgG labeled by HRP and visualized using 0.05% DAB.
-
Immunofluorescence staining of PC-3 cell with CSB-PA621886ESR1HU at 1:25, counter-stained with DAPI. The cells were fixed in 4% formaldehyde and and permeated by 0.2% TritonX-100 for 15 min. Then 10% normal goat serum to block non-specific protein-protein interactions . The cells were then incubated with the antibody overnight at 4℃. The secondary antibody was Alexa Fluor 488-congugated AffiniPure Goat Anti-Rabbit IgG(H+L).
-
-
其他:
產品詳情
-
產品描述:
The peptide mapping within amino acids 27-264 of the recombinant human CHRNA2 is used to immunize rabbits to generate the anti-CHRNA2 antibody. The resulting antibody is a polyclonal antibody and occurs as an unconjugated IgG. It underwent antigen affinity purification. And it is only reactive with human CHRNA2 protein, a type of receptor best known for modulating nicotine dependence in brain cells. Recent findings have been shown that CHRNA2 plays a role in energy metabolism. This CHRNA2 antibody is suitable for the detection of the CHRNA2 protein in ELISA, WB, and IHC applications.
-
產品名稱:Rabbit anti-Homo sapiens (Human) CHRNA2 Polyclonal antibody
-
Uniprot No.:
-
基因名:CHRNA2
-
別名:ACHA2_HUMAN antibody; AChR antibody; Cholinergic receptor nicotinic alpha 2 antibody; Chrna2 antibody; Neuronal acetylcholine receptor protein subunit alpha 2 antibody; Neuronal acetylcholine receptor subunit alpha-2 antibody; Nicotinic Acetylcholine Receptor alpha 2 antibody
-
宿主:Rabbit
-
反應種屬:Human
-
免疫原:Recombinant Human Neuronal acetylcholine receptor subunit alpha-2 protein (27-264AA)
-
免疫原種屬:Homo sapiens (Human)
-
標記方式:Non-conjugated
-
克隆類型:Polyclonal
-
抗體亞型:IgG
-
純化方式:Antigen Affinity Purified
-
濃度:It differs from different batches. Please contact us to confirm it.
-
保存緩沖液:Preservative: 0.03% Proclin 300
Constituents: 50% Glycerol, 0.01M PBS, PH 7.4 -
產品提供形式:Liquid
-
應用范圍:ELISA, WB, IHC, IF
-
推薦稀釋比:
Application Recommended Dilution WB 1:1000-1:5000 IHC 1:20-1:200 IF 1:20-1:200 -
Protocols:
-
儲存條件:Upon receipt, store at -20°C or -80°C. Avoid repeated freeze.
-
貨期:Basically, we can dispatch the products out in 1-3 working days after receiving your orders. Delivery time maybe differs from different purchasing way or location, please kindly consult your local distributors for specific delivery time.
-
用途:For Research Use Only. Not for use in diagnostic or therapeutic procedures.
相關產品
靶點詳情
-
功能:After binding acetylcholine, the AChR responds by an extensive change in conformation that affects all subunits and leads to opening of an ion-conducting channel across the plasma membrane.
-
基因功能參考文獻:
- A crystal structure of a human neuronal CHRNA2 extracellular domain in pentameric assembly has been reported. PMID: 27493220
- The rare variants in CHRNA2 were significantly associated with smoking status. PMID: 25450229
- a heterozygous single-nucleotide substitution in CHRNA2 gene (c.1126 C>T; p. Arg376Trp) in subjects with benign familial infantile seizures PMID: 25847220
- CHRNA2 mutations play a causative role in autosomal dominant nocturnal frontal lobe epilepsy (ADNFLE). PMID: 25770198
- Results show that D478E variation in nAChR alpha2 subunit increases the peak current responses of both alpha2beta2- and alpha2beta4-nAChRs; but the D478N variation in nAChR alpha2 subunit only increases the peak current responses of alpha2beta2-nAChRs PMID: 24950454
- Level of cigarettes per day during adolescence and young adulthood is associated with CHRNB3A6, CHRNA5A3B4, and CHRNA2 PMID: 23943838
- Results indicate that the CHRNA2 signal peptide mutation T22I modulates the function of both alpha2beta2- and alpha2beta4-nAChR and decreases sensitivities to nicotine and acetylcholine, and quite possibly increasing susceptibility to nicotine dependence PMID: 24467848
- findings indicate that both CHRNA2 and CHRNA6 play a significant role in the etiology of ND in AA and EA smokers PMID: 24253422
- mutations of CHRNB2 and CHRNA2 genes may be rare in Chinese autosomal dominant nocturnal frontal lobe epilepsy (ADNFLE) population. PMID: 21287502
- How mutations in the nAChRs can cause autosomal dominant nocturnal frontal lobe epilepsy PMID: 12121305
- A new CHRNA2 mutation markedly increases the receptor sensitivity to acetylcholine, indicating that the nicotinic alpha 2 subunit alteration is the underlying cause. PMID: 16826524
- data demonstrate the rarity of the identified CHRNA2 mutations in nocturnal frontal lobe epilepsy patients, supporting the recently reported hypothesis of a restricted role for this gene in the disease PMID: 18226955
- The CHRNA2 rs2043063 SNP might be a risk factor for overweight/obesity in Koreans PMID: 18588430
- Results suggest that neither CHRNA4 nor CHRNB2 plays a major role in Japanese methamphetamine-use disorder. PMID: 18991851
- Pleiotropic functional effects of the first epilepsy-associated mutation in the human CHRNA2 gene PMID: 19383498
顯示更多
收起更多
-
相關疾病:Epilepsy, nocturnal frontal lobe, 4 (ENFL4)
-
亞細胞定位:Cell junction, synapse, postsynaptic cell membrane; Multi-pass membrane protein. Cell membrane; Multi-pass membrane protein.
-
蛋白家族:Ligand-gated ion channel (TC 1.A.9) family, Acetylcholine receptor (TC 1.A.9.1) subfamily, Alpha-2/CHRNA2 sub-subfamily
-
數據庫鏈接:
Most popular with customers
-
-
YWHAB Recombinant Monoclonal Antibody
Applications: ELISA, WB, IHC, IF, FC
Species Reactivity: Human, Mouse, Rat
-
Phospho-YAP1 (S127) Recombinant Monoclonal Antibody
Applications: ELISA, WB, IHC
Species Reactivity: Human
-
-
-
-
-